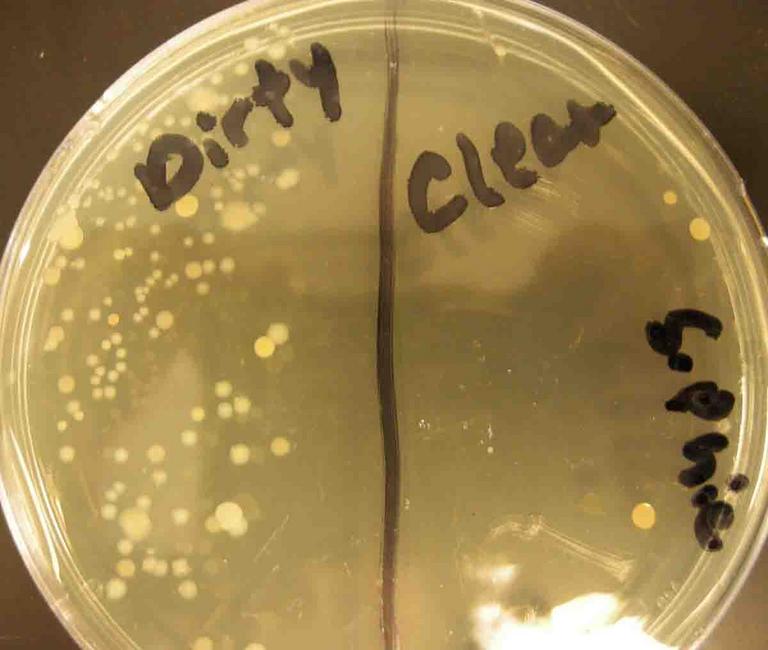

| ||||
Does the Dishwasher Kill Bacteria?
SIMPLE HOME MICROBIOLOGY EXPERIMENT
Science for Kids of All Ages from Science Prof Online
Article Summary: Yes, automatic dishwashers do kill bacteria present on dirty dishes! This page presents some simple home microbiology experiments that you can do to investigate the effectiveness of various ways of cleaning dishes. See the results of our own experiment at the bottom of this page.
Does the Dishwasher Really Sanitize Dishes?
SPO VIRTUAL CLASSROOMS
 | ||||||
 | ||||||
SPO is a FREE science education website. Donations are key in helping us provide this resource with fewer ads.
Please help!
(This donation link uses PayPal on a secure connection.)
Page last updated 10/2014
There are many different interesting questions you can investigate with the supplies listed in this article. A few examples:
- How well do your household cleaners work to eliminate bacteria? Obtain a sample from an area before and after cleaning.
- How clean are your childrens' toys?
- Does hand washing work better than hand sanitizer?
3. Label the bottom half of the Petri dish, the side that contains the media. Draw a line down the center of the Petri dish bottom. Write "dirty" on one side of the line and "clean on the other. Also include your name, date and how long the dirty dishes have been sitting in the dish washer.
4. Carefully remove sterile swab from packaging. Be sure not to let it touch anything.
5. Open the dishwasher containing dirty dishes, and run the swab over the dishes and the inside surface of the dishwasher.
6. Lift the top off the Petri dish without setting it down (This could contaminate).
7. Take the swab and very gently run it over the surface of the TSY on the side marked "dirty". Use a tight back-and-forth pattern to make sure the swab contacts most of the agar on that side of the plate. Be careful not to touch the "clean" side.
Children using a sterile swab to obtain bacterial sample from dirty dishes in dishwasher.
8. Place the cover back on the Petri dish. Then put the Petri dish in a sealed plastic bag.
9. Run the dishwasher on the cycle you would like to test. For example, perhaps, if your dishwasher has it, you want to test the cycle actually labeled "sanitizing cycle", or you want to test with hot water and heated dry, or hot water and air dry with no heat. There are many possibilities for various experiments.
10. When the dishes have dried and cooled, retrieve your Petri dish and remove it from the bag.
11. Obtain another sterile swab for your "clean" sample. Run the swab over the same dishes and area of the dishwasher as you did for the "dirty" sample.
12. Run this swab over media on the side of the Petri dish labeled "clean". Use the same gentile back-and-forth streaking pattern that you did for the dirty sample. Be sure not to let this swab touch the "dirty" side of the plate at all.
13. Place the Petri dish back in the plastic bag and in a warm location, such as the top of the refrigerator. It is best to incubate the plate bottom side up. Keep the plate out of the reach of children and pets. From this point on, always keep the Petri dish in the plastic bag.
14. Check the plate daily for growth. Growth is represented by bacterial colonies. A colony is million of bacteria that have, over time and many cell divisions, arisen from one bacterium. Once you begin to see growth, you may want to photograph the plate every day to note changes. See the completed experiment below for example photos.
15. After you've obtained the data you need, throw away the plate, in its sealed bag.
Results of Our Dishwasher Experiment
My two youngest children and I recently ran this experiment. The photos below and their captions reveal the results. Keep in mind that the amount and type of bacteria in a dirty dish washer depend on many things, including the type of food prepared, the amount of time the dirty dishes sat in the dishwasher.
Check back soon! We will be adding experimental results of how well hand washing dishes works to kill bacteria.
Supplies Required for Dish Washing Experiment
- Petri dishes
- Bacterial growth media (TSY Trypic Soy Agar is fine)
- sterile cotton swabs (2 for each Petri dish)
- safety glasses
- permanent marker
The company Home Science Tools offers a nice bacteria experiment kit for less than $30, with most everything you need, but the kit does require that you pour the media into the Petri dishes. To do this, you must use aseptic technique to avoid contaminating the media. See the video to the left for a demonstration of how to aseptically pour agar and follow the instructions supplied by the company you buy your supplies from.
Experimental Procedure for Dishwasher
1. If you need to pour your TSY media into Petri dishes (also called "plates"), do that first, with safety goggles on. Watch the video to the left and follow manufacturers instructions. If you are able to purchase pre-poured plates, skip steps 1 & 2.
2. Wait for the media to cool and become solid (like Jello).
How to Pour TSY Media Into Petri Dishes
(Put your goggles on first!)
Both of these plates and the one pictured above in the procedure instructions were taken from the same dishwasher run with hot water and heated dry. Two of the three plate have no bacterial growth. The plate with bacterial growth was prepared by budding 6-year-old scientist, so the growth on the "clean" side may have resulted from contamination or technique.
The plate to the left was prepared on a different occasion. Dishes had been sitting in the dishwasher for 24 hours before the cycle ran, hot wash and air dry with no heat.
 | ||||
ANOTHER SPO
HOME SCIENCE PROJECT
PLANARIAN FLATWORMS
We are keeping Dugesia! These cute, cross-eyed "immortal worms" have an almost limitless ability to regenerate. Even a small piece of one can grow onto a new worm!
to meet our flatworms!
You Can Do Microbiology at Home!
How clean are your dishes? Your kitchen? Your bathroom? With a few inexpensive science supplies your family or class can test for the presence of bacteria in different areas of the home. This page presents instructions for testing the effectiveness of different ways of cleaning dishes, as well as results of some of the tests we've run.
There are many excellent books full of easy, fun home science experiments. This one is available on Amazon for less than $10.
Additional Microbial Control & Kid Science Resources
- Microbiology In the Home: Tips To Sanitize Your House and Keep Your Family Healthy, Household Microbiology article from Science Prof Online.
- Does the Shark PRO Steam and Spray Mop Kill Bacteria on Floors? from Science Prof Online. Compare the experiment on this page (steam alone) to a mop that uses steam and cleanser.)
- Microbial Control Laboratory Exercise Main Page from the Virtual Microbiology Classroom.
- Home School and Classroom Science for Kids from Science Prof Online: The home experiments of a science teacher and her grade school-age children: tadpole metamorphosis, planaria flatworm experiments, microscopic pond life, microbiology for kids and links to child-friendly resources for exploring science.
Safety Measures When Working With Live Bacteria
Please read this section carefully before carrying out the experiment outlined above. Although these plates will be growing bacteria present on hands, once the bacteria begin growing on the agar plates, they will be present in much higher numbers than a person would normally encounter. Therefore, there are some important safety precautions to keep in mind:
- Wear safety goggles and protective gloves when handling plates that are growing bacteria.
- Never open the plates after placing the sample on the agar. Bacteria will be present in large numbers. Some can become airborne and be breathed in or land on areas of the body close to an open plate.
- Keep plates out of the reach of small children and pets.Talk to children about these safety precautions and make sure they know not to ever handle the plates without adult supervision.
- You may place a rubber band around the plates to reduce the likelihood that they will accidentally fall open.
- The top of the refrigerator can be a good place to store incubating plates, as it is up high and usually a bit warm.
- Placing incubating plates in open plastic bag (so aerobic bacteria can get oxygen) is a good measure to keep them safer and reduce odor (bacteria are stinky).
- When the experiment is finished, and you are done with the plates, place them in a zipped up plastic bag (Zip-loc) in the trash. They will run out of food and water eventually and die, but not before generating a lot of stink.
 | ||||
Young children are natural born scientists, full of curiosity! Join the at-home experiments and explorations of a scientist mom & her kids.
ATTENTION!: Please see the section on Safety Measures for Working with Live Bacteria
before attempting this experiment yourself!
The SPO website is best viewed in Microsoft Explorer, Google Chrome or Apple Safari.
BULLFROG UPDATE!
Latest Tadpole News
10/26/14
Although two of our tadpoles fully morphed into frogs, only one survived and thrives, Lumpy! He is now a little bullfrog and loves to eat chopped earthworms!!
> Go to Tadpole